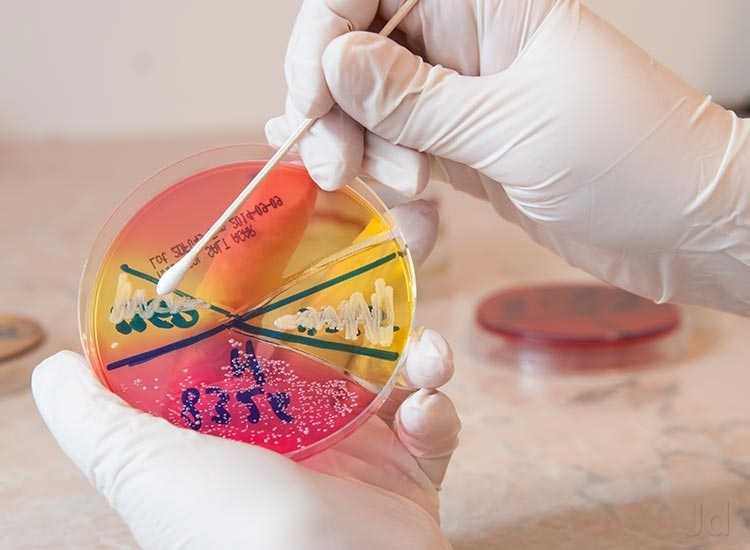

Type: Diagnostic / Genomics Labs
Address: Revathi Lodge Building, Turavanur Road, Near Dist Hospital.
Village/Taluka/Block: Chitradurga
District: Chitradurga
State: Karnataka
Pin Code: 577501
Landline 1: 08194- 220727
Working Time: 7:00 am to 9:00 pm
Holidays: Sunday
Facilities Available: Blood Biochemical, Pathology / Parasitology